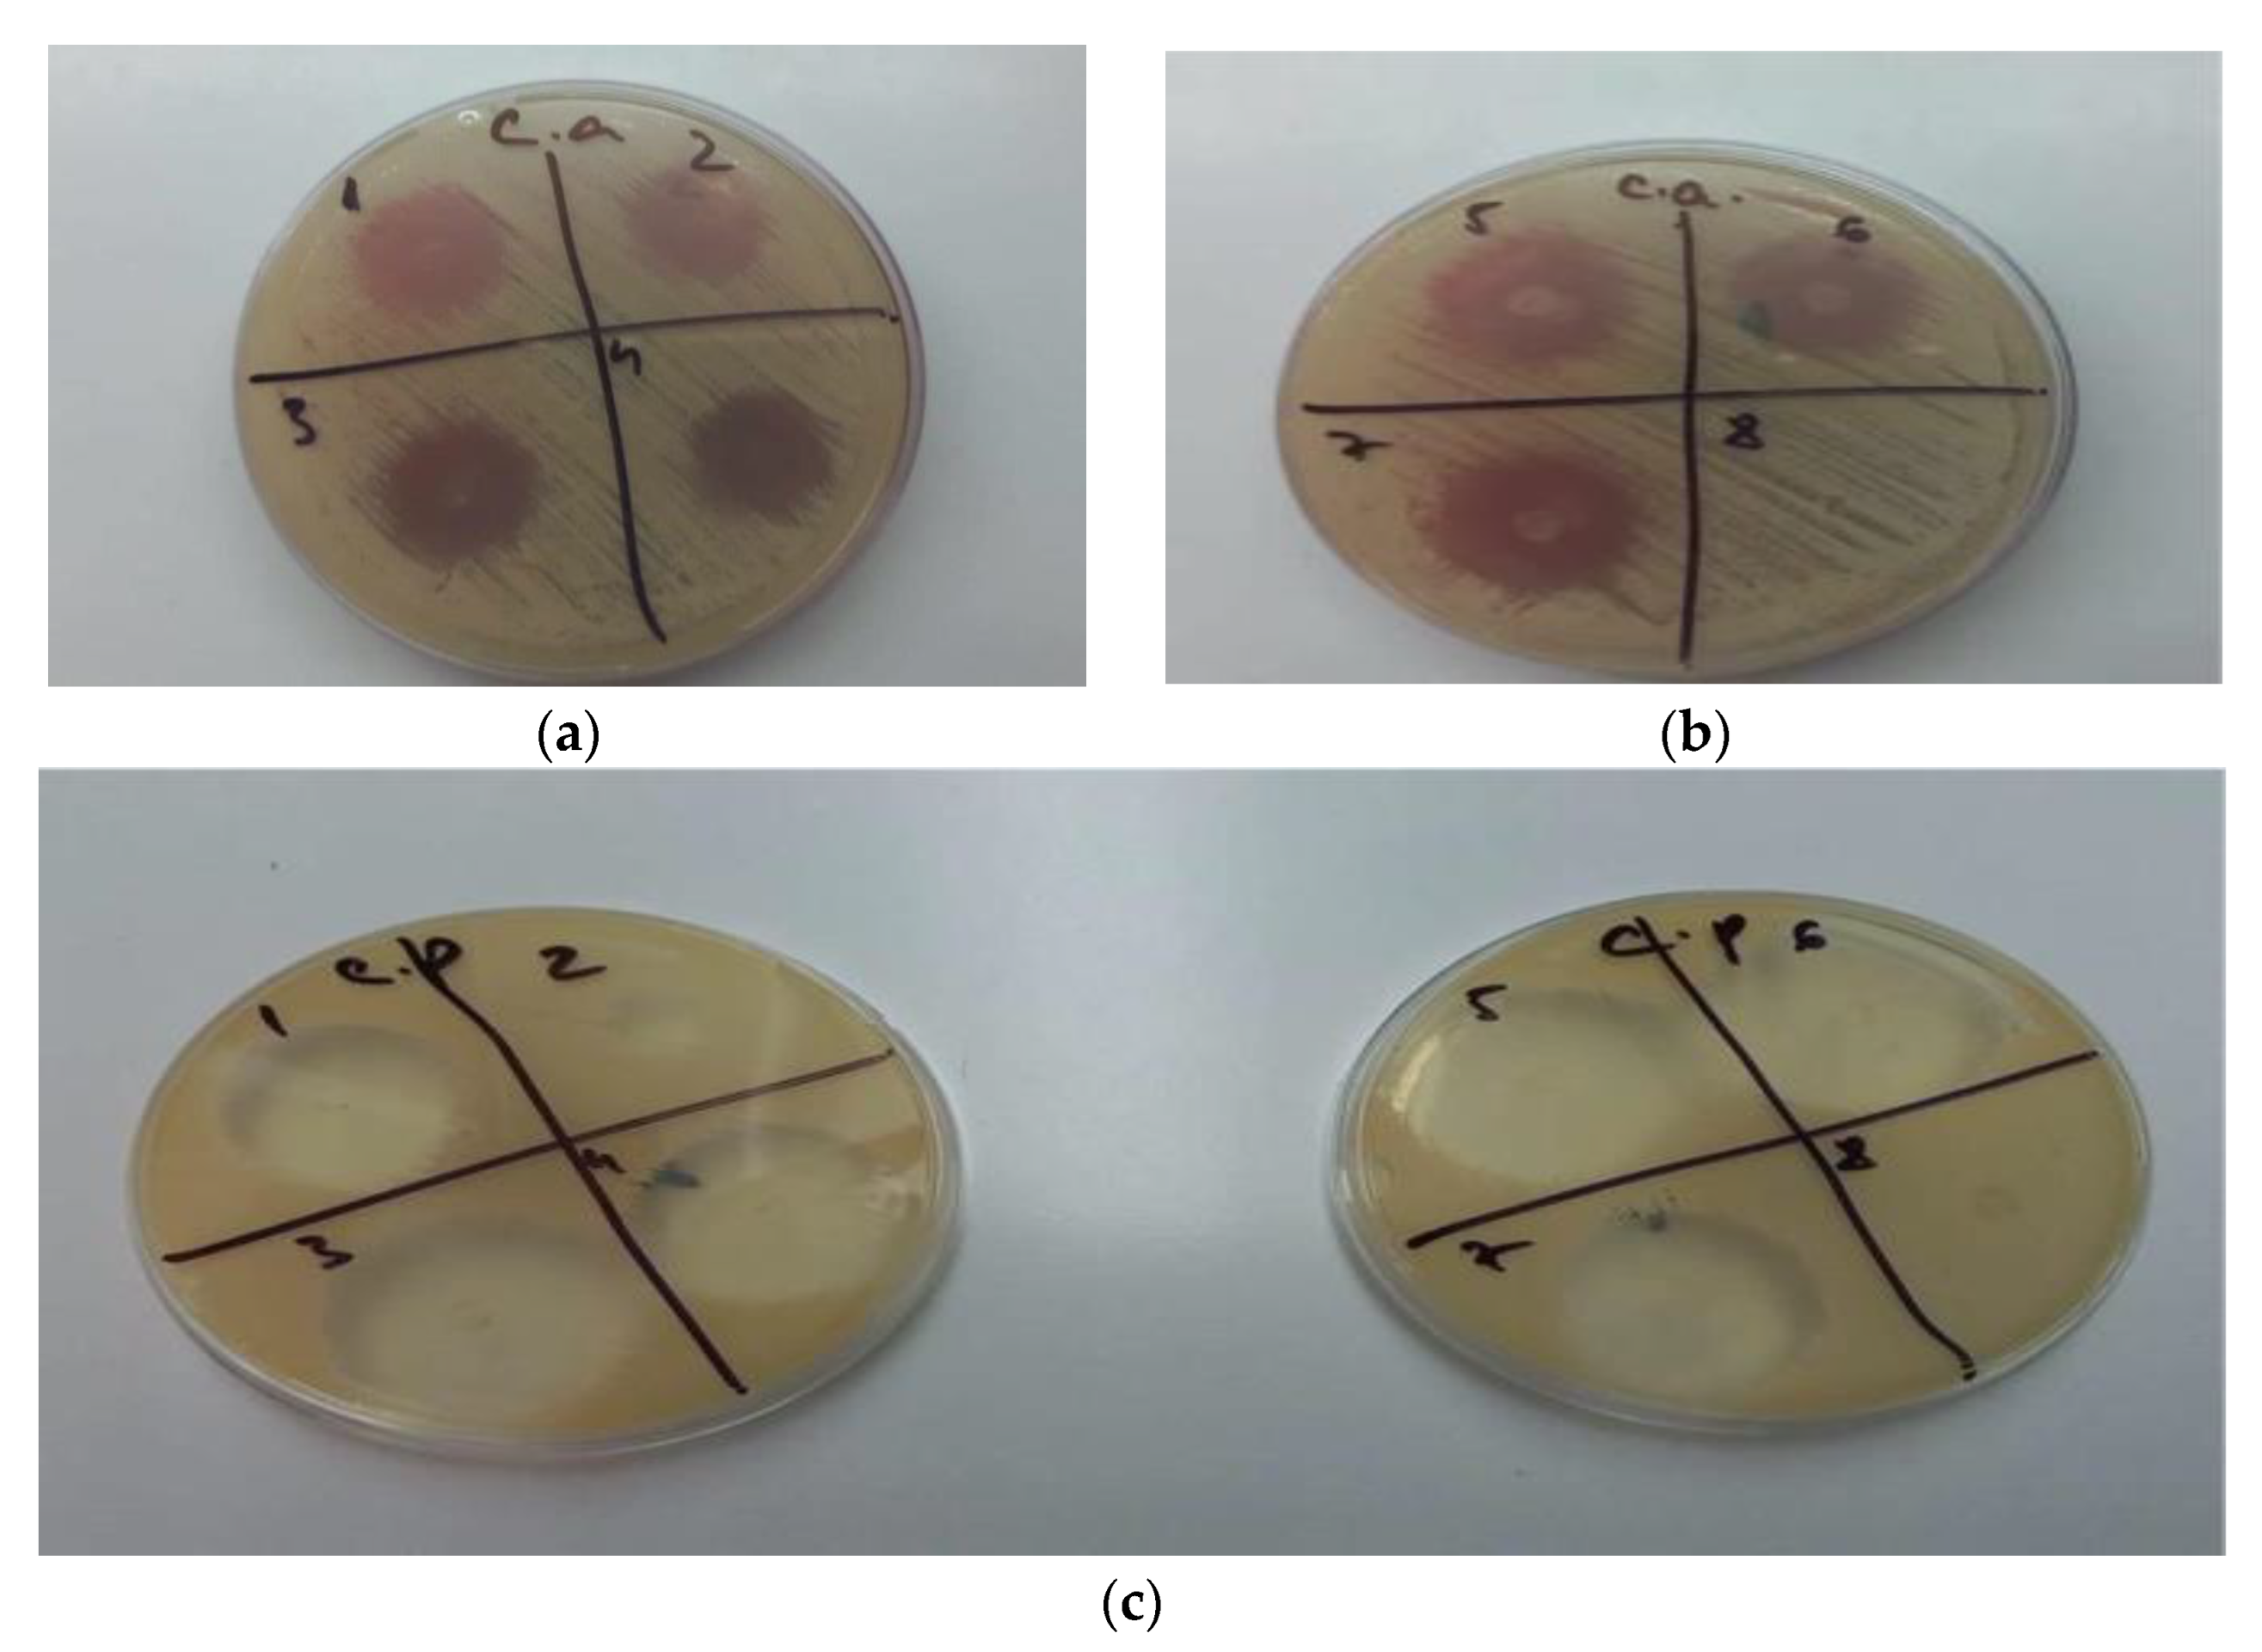

Structural Characterization and Optimization of a Miconazole Oral Gel
Abstract
1. Introduction
2. Materials and Methods
2.1. Gel Preparation
2.2. Developing the Optimal Formulation Using a D-Optimal Design
2.2.1. Consistency
2.2.2. Spreadability
2.2.3. Rheological Study
2.3. Drug Content
2.4. Antifungal Activity
3. Results and Discussion
3.1. Appearance
3.2. Evaluation of the Dependent Parameters Using a D-Optimal Design
3.2.1. Consistency
3.2.2. Spreadability
3.2.3. Rheology Study
3.3. Drug Content
3.4. Antifungal Activity
3.5. Optimization of the MIC Gel Formulation
3.5.1. Uniformity of Content
3.5.2. Antifungal Activity of the Optimized Gel
4. Conclusions
Supplementary Materials
Author Contributions
Funding
Institutional Review Board Statement
Informed Consent Statement
Conflicts of Interest
References
- Simões, A.; Veiga, F.; Vitorino, C.; Figueiras, A. A Tutorial for Developing a Topical Cream Formulation Based on the Quality by Design Approach. J. Pharm. Sci. 2018, 107, 2653–2662. [Google Scholar] [CrossRef] [PubMed]
- Guy, R.H.; Hadgraft, J.; Bucks, D.A. Transdermal drug delivery and cutaneous metabolism. Xenobiotica 1987, 17, 325–343. [Google Scholar] [CrossRef] [PubMed]
- Shah, V.P.; Yacobi, A.; Rădulescu, F.Ş.; Miron, D.S.; Lane, M.E. A science based approach to topical drug classification system (TCS). Int. J. Pharm. 2015, 491, 21–25. Available online: https://www.sciencedirect.com/science/article/pii/S0378517315005220 (accessed on 1 October 2022). [CrossRef] [PubMed]
- Council of Europ. European Pharmacopoeia, 10th ed.; Council f Europ: Strasbourg, France, 2021. [Google Scholar]
- Lee, S.H.; Jeong, S.K.; Ahn, S.K. An update of the defensive barrier function of skin. Yonsei Med. J. 2006, 47, 293–306. [Google Scholar] [CrossRef] [PubMed]
- Zaki, R.M.; Ibrahim, M.A.; Alshora, D.H.; Abou El Ela, A.E.S. Formulation and Evaluation of Transdermal Gel Containing Tacrolimus-Loaded Spanlastics: In Vitro, Ex Vivo and In Vivo Studies. Polymers 2022, 14, 1528. [Google Scholar] [CrossRef]
- Jeong, W.Y.; Kwon, M.; Choi, H.E.; Kim, K.S. Recent advances in transdermal drug delivery systems: A review. Biomater. Res. 2021, 25, 24. [Google Scholar] [CrossRef]
- Andretto, V.; Rosso, A.; Briançon, S.; Lollo, G. Nanocomposite systems for precise oral delivery of drugs and biologics. Drug Deliv. Transl. Res. 2021, 11, 445–470. [Google Scholar] [CrossRef]
- Chou, W.H.; Galaz, A.; Jara, M.O.; Gamboa, A.; Morales, J.O. Drug-loaded lipid-core micelles in mucoadhesive films as a novel dosage form for buccal administration of poorly water-soluble and biological drugs. Pharmaceutics 2020, 12, 1168. [Google Scholar] [CrossRef]
- Groeger, S.; Meyle, J. Oral Mucosal Epithelial Cells. Front. Immunol. 2019, 10, 208. Available online: https://www.frontiersin.org/articles/10.3389/fimmu.2019.00208 (accessed on 14 October 2022). [CrossRef]
- Brizuela, M.; Winters, R. Histology, Oral Mucosa; StatPearls Publishing: Treasure Island, FL, USA, 2022. [Google Scholar]
- Nicolau, G.; Năstase, C.; Terehov, A. Morpho-functional aspects of mucous membrane of the oral cavity (review). Med. Stomatol. 2017, 45, 43–46. [Google Scholar]
- Ahmad, Z.; Salman, S.; Khan, S.A.; Amin, A.; Rahman, Z.U.; Al-Ghamdi, Y.O.; Akhtar, K.; Bakhsh, E.M.; Khan, S.B. Versatility of Hydrogels: From Synthetic Strategies, Classification, and Properties to Biomedical Applications. Gels 2022, 8, 167. Available online: https://www.mdpi.com/2310-2861/8/3/167/htm (accessed on 14 October 2022). [CrossRef]
- Bustamante-Torres, M.; Romero-Fierro, D.; Arcentales-Vera, B.; Palomino, K.; Magaña, H.; Bucio, E. Hydrogels Classification According to the Physical or Chemical Interactions and as Stimuli-Sensitive Materials. Gels 2021, 7, 182. Available online: https://www.mdpi.com/2310-2861/7/4/182/htm (accessed on 14 October 2022). [CrossRef] [PubMed]
- Yasin, H.; Yousaf, Z. Synthesis of hydrogels and their emerging role in pharmaceutics. In Biomedical Applications of Nanoparticles; William Andrew Publishing: Norwich, NY, USA, 2019; pp. 163–194. [Google Scholar]
- Djabourov, M. Gels. In NMR and MRI of Gels; The Royal Society of Chemistry: London, UK, 2020; pp. 1–44. [Google Scholar]
- Hosmani, A.; Thorat, Y.S.; Kasture, P.V. Carbopol and its Pharmaceutical Significance: A Review. Pharm. Rev. 2006, 1, 4. [Google Scholar]
- Puranik, P.K.; Panzade, P. Carbopol Polymers: A Versatile Polymer for Pharmaceutical Applications. Res. J. Pharm. Technol. 2010, 3, 672–675. [Google Scholar]
- Kaur, G.; Grewal, J.; Jyoti, K.; Jain, U.K.; Chandra, R.; Madan, J. Oral controlled and sustained drug delivery systems: Concepts, advances, preclinical, and clinical status. In Drug Targeting and Stimuli Sensitive Drug Delivery Systems; William Andrew Publishing: Norwich, NY, USA, 2018; pp. 567–626. Available online: https://www.sciencedirect.com/science/article/pii/B978012813689800015X (accessed on 21 October 2022).
- Anlar, S.; Capan, Y.; Hincal, A.A. Physico-chemical and bioadhesive properties of polyacrylic acid polymers. Pharmazie 1993, 48, 285–287. [Google Scholar] [PubMed]
- Safitri, F.; Nawangsari, D.; Febrina, D. Overview: Application of Carbopol 940 in Gel. Proc. Int. Conf. Health Med. Sci. 2021, 34, 80–84. [Google Scholar]
- Popovici, I.; Lupuleasa, D. Pharmaceutical Technology Vol. 2; Polirom Publishing: Iași, Romania, 2008. [Google Scholar]
- Drozd, K.V.; Manin, A.N.; Boycov, D.E.; Perlovich, G.L. Simultaneous Improvement of Dissolution Behavior and Oral Bioavailability of Antifungal Miconazole via Cocrystal and Salt Formation. Pharmaceutics 2022, 14, 1107. [Google Scholar] [CrossRef]
- Sreedhara Swamy, K.H.; Sirsi, M.; Ramananda Rao, G.R. Studies on the Mechanism of Action of Miconazole: Effect of Miconazole on Respiration and Cell Permeability of Candida albicans. Antimicrob. Agents Chemother. 1974, 5, 420–425. [Google Scholar] [CrossRef][Green Version]
- Heel, R.C.; Brogden, R.N.; Pakes, G.E.; Speight, T.M.; Avery, G.S. Miconazole: A Preliminary Review of its Therapeutic Efficacy in Systemic Fungal Infections. Drugs 1980, 19, 7–30. [Google Scholar] [CrossRef]
- Chen, W.; Wu, W. Development and evaluation of miconazole mucoadhesive tablets for oropharyngeal candidiasis. Trop. J. Pharm. Res. 2017, 16, 2325–2330. [Google Scholar]
- Piérard, G.E.; Hermanns-Lê, T.; Delvenne, P.; Piérard-Franchimont, C. Miconazole, a pharmacological barrier to skin fungal infections. Expert Opin. Pharmacother. 2012, 13, 1187–1194. [Google Scholar] [CrossRef] [PubMed]
- Cope, J.E. Mode of action of miconazole on Candida albicans: Effect on growth, viability and K+ release. J. Gen. Microbiol. 1980, 119, 245–251. [Google Scholar] [CrossRef] [PubMed]
- Taudorf, E.H.; Jemec, G.B.E.; Hay, R.J.; Saunte, D.M.L. Cutaneous candidiasis—An evidence-based review of topical and systemic treatments to inform clinical practice. J. Eur. Acad. Dermatol. Venereol. 2019, 33, 1863–1873. [Google Scholar] [CrossRef] [PubMed]
- Stevens, D.A. Miconazole in the Treatment of Coccidioidomycosis. Drugs 1983, 26, 347–354. [Google Scholar] [CrossRef]
- Zhang, L.W.; Fu, J.Y.; Hua, H.; Yan, Z.M. Efficacy and safety of miconazole for oral candidiasis: A systematic review and meta-analysis. Oral Dis. 2016, 22, 185–195. [Google Scholar] [CrossRef]
- Mendes, A.I.; Silva, A.C.; Catita, J.A.M.; Cerqueira, F.; Gabriel, C.; Lopes, C.M. Miconazole-loaded nanostructured lipid carriers (NLC) for local delivery to the oral mucosa: Improving antifungal activity. Colloids Surf. B Biointerfaces 2013, 111, 755–763. [Google Scholar] [CrossRef]
- Ramadan, A. Formulation and Evaluation of Bioadhesive Gels Containing Miconazole Nitrate. J. Appl. Sci. Res. 2008, 4, 1052–1065. [Google Scholar]
- Satish Kumar, N.; Seetharaman, S. Design, development and evaluation of miconazole nitrate topical gel for fungal infections. Int. J. Pharm. Sci. Res. 2015, 6, 1266–1272. [Google Scholar]
- Gandhi, A.; Roy, C. Quality by design (QbD) in pharmaceutical industry: Tools, perspectives and challenges. PharmaTutor 2016, 4, 12–20. Available online: https://www.pharmatutor.org/articles/quality-by-design-qbd-in-pharmaceutical-industry-tools-perspectives-and-challenges (accessed on 22 October 2022).
- Hani, U.; Rahamathulla, M.; Osmani, R.A.M.; Begum, Y.; Wahab, S.; Ghazwani, M. Development and Characterization of Oral Raft Forming In Situ Factorial Design. Polymers 2022, 14, 2520. [Google Scholar] [CrossRef]
- Rizg, W.Y.; Naveen, N.R.; Kurakula, M.; Bukhary, H.A.; Safhi, A.Y.; Alfayez, E. QbD Supported Optimization of the Alginate-Chitosan Nanoparticles of Simvastatin in Enhancing the Anti-Proliferative Activity against Tongue Carcinoma. Gels 2022, 8, 103. [Google Scholar] [CrossRef] [PubMed]
- Yu, L.X.; Amidon, G.; Khan, M.A.; Hoag, S.W.; Polli, J.; Raju, G.K.; Woodcock, J. Understanding Pharmaceutical Quality by Design. AAPS J. 2014, 16, 771. Available online: https://pubmed.ncbi.nlm.nih.gov/24854893/ (accessed on 22 October 2022). [CrossRef] [PubMed]
- Hosny, K.M.; Naveen, N.R.; Kurakula, M.; Sindi, A.M.; Sabei, F.Y.; Fatease, A.A.; Jali, A.M.; Alharbi, W.S.; Mushtaq, R.Y.; Felemban, M.; et al. Design and Development of Neomycin Sulfate Gel Loaded with Solid Lipid Nanoparticles for Buccal Mucosal Wound Healing. Gels 2022, 8, 385. [Google Scholar] [CrossRef] [PubMed]
- Zhang, L.; Mao, S. Application of quality by design in the current drug development. Asian J. Pharm. Sci. 2017, 12, 1–8. [Google Scholar] [CrossRef]
- Mendonça, A.; Santos, H.; Franco-Duarte, R.; Sampaio, P. Fungal infections diagnosis—Past, present and future. Res. Microbiol. 2022, 173, 103915. [Google Scholar] [CrossRef]
- Mota Fernandes, C.; Dasilva, D.; Haranahalli, K.; McCarthy, J.B.; Mallamo, J.; Ojima, I. The Future of Antifungal Drug Therapy: Novel Compounds and Targets. Antimicrob. Agents Chemother. 2021, 65, 1719–1720. [Google Scholar] [CrossRef]
- Vlad, R.-A.; Antonoaea, P.; Todoran, N.; Rédai, E.-M.; Bîrsan, M.; Muntean, D.-L. Development and Evaluation of Cannabidiol Orodispersible Tablets Using a 2(3)-Factorial Design. Pharmaceutics 2022, 14, 1467. [Google Scholar] [CrossRef]
- Zhang, D. A Coefficient of Determination for Generalized Linear Models. Am. Stat. 2016, 71, 310–316. [Google Scholar] [CrossRef]
- Zen, N.I.M.; Abd Gani, S.S.; Shamsudin, R.; Masoumi, H.R.F. The Use of D-Optimal Mixture Design in Optimizing Development of Okara Tablet Formulation as a Dietary Supplement. Sci. World J. 2015, 2015, 684319. [Google Scholar]
- Ismail, T.A.; Shehata, T.M.; Mohamed, D.I.; Elsewedy, H.S.; Soliman, W.E. Quality by Design for Development, Optimization and Characterization of Brucine Ethosomal Gel for Skin Cancer Delivery. Molecules 2021, 26, 3454. [Google Scholar] [CrossRef]
- Mut, A.M.; Vlaia, L.; Coneac, G.; Olariu, I.; Vlaia, V.; Stănciulescu, C.; Mitu, M.A.; Szabadai, Z.; Lupuleasa, D. Chitosan/HPMCbased hydrogels containing essential oils for topical delivery of fluconazole: Preliminary studies. Farmacia 2018, 66, 248–256. [Google Scholar]
- Parashar, B.; Kabra, A. Formulation and Evaluation of Gel Containing Miconazole Nitrate an Antifungal Agent. Int. J. Pharm. Res. 2013, 2, 18. [Google Scholar]
- Rai, V.K.; Yadav, N.P.; Sinha, P.; Mishra, N.; Luqman, S.; Dwivedi, H.; Kymonil, K.M.; Saraf, S.A. Development of cellulosic polymer based gel of novel ternary mixture of miconazole nitrate for buccal delivery. Carbohydr. Polym. 2014, 103, 126–133. [Google Scholar] [CrossRef] [PubMed]
- Narayana Charyulu, R.; Parvathy Devi, P.; Jobin, J.; Shetty, V. Formulation and Evaluation of Mucoadhesive Oral Gel Containing Miconazole Nitrate for Oral Candidiasis. Res. J. Pharm. Technol. 2013, 6, 1251–1257. [Google Scholar]
- Sangeetha, S.S.; Kumar, P.; Karki, R. Formulation and evaluation of bioadhesive miconazole nitrate gel for vaginal candidiasis. Int. J. Pharm. Technol. 2012, 4, 3825–3838. [Google Scholar]
- Destruel, P.L.; Zeng, N.; Maury, M.; Mignet, N.; Boudy, V. In vitro and in vivo evaluation of in situ gelling systems for sustained topical ophthalmic delivery: State of the art and beyond. Drug Discov. Today 2017, 22, 638–651. [Google Scholar] [CrossRef]
- Irimia, T.; Dinu-Pîrvu, C.-E.; Ghica, M.V.; Lupuleasa, D.; Muntean, D.-L.; Udeanu, D.I.; Popa, L. Chitosan-Based In Situ Gels for Ocular Delivery of Therapeutics: A State-of-the-Art Review. Mar. Drugs 2018, 16, 373. [Google Scholar] [CrossRef]
- Ghica, M.V.; Hîrjău, M.; Lupuleasa, D.; Dinu-Pîrvu, C.-E. Flow and Thixotropic Parameters for Rheological Characterization of Hydrogels. Molecules 2016, 21, 786. [Google Scholar] [CrossRef]
- Iqbal, Z.; Zafar, M.S. Role of antifungal medicaments added to tissue conditioners: A systematic review. J. Prosthodont. Res. 2016, 60, 231–239. [Google Scholar] [CrossRef]
- Radnai, M.; Whiley, R.; Friel, T.; Wright, P.S. Effect of antifungal gels incorporated into a tissue conditioning material on the growth of Candida albicans. Gerodontology 2010, 27, 292–296. [Google Scholar] [CrossRef]
- El Maghraby, G.M.M.; Williams, A.C.; Barry, B.W. Interactions of surfactants (edge activators) and skin penetration enhancers with liposomes. Int. J. Pharm. 2004, 276, 143–161. [Google Scholar] [CrossRef] [PubMed]
- Pegoraro, N.S.; Camponogara, C.; Gehrcke, M.; Giuliani, L.M.; da Silva, D.T.; Maurer, L.H.; Dias, P.; Emanuelli, T.; Cruz, L.; Oliveira, S.M. Oleic acid-containing semisolid dosage forms exhibit in vivo anti-inflammatory effect via glucocorticoid receptor in a UVB radiation-induced skin inflammation model. Inflammopharmacology 2020, 28, 773–786. [Google Scholar] [CrossRef] [PubMed]
- Pinzaru, I.; Tanase, A.; Enatescu, V.; Coricovac, D.; Bociort, F.; Marcovici, I.; Watz, C.; Vlaia, L.; Soica, C.; Dehelean, C. Proniosomal Gel for Topical Delivery of Rutin: Preparation, Physicochemical Characterization and In Vitro Toxicological Profile Using 3D Reconstructed Human Epidermis Tissue and 2D Cells. Antioxidants 2021, 10, 85. [Google Scholar] [CrossRef] [PubMed]
- Afsari, B.; Razavi Aghjeh, M.K.; Hasanpour, M. Evolution of morphology and morphology stability in PP/PA6/EPDM-g-MA reactive ternary blends using viscoelastic measurements. Rheol. Acta 2020, 59, 399–414. [Google Scholar] [CrossRef]

| Ingredient% (w/w) | Gel | G1 | G2 | G3 | G4 | G5 | G6 | G7 |
|---|---|---|---|---|---|---|---|---|
| Miconazole nitrate 1/Gels Series | M | 2 | 2 | 2 | 2 | 2 | 2 | 2 |
| O | - | - | - | - | - | - | - | |
| CBP 940 2 | 0.8 | 1 | 0.8 | 1 | 0.9 | 0.9 | 0.9 | |
| Sodium hydroxide 3 | 0.3 | 0.3 | 0.4 | 0.4 | 0.35 | 0.35 | 0.35 | |
| Glycerol 4 | 3 | 3 | 3 | 3 | 3 | 3 | 3 | |
| Sucralose 5 | 0.05 | 0.05 | 0.05 | 0.05 | 0.05 | 0.05 | 0.05 | |
| Citric acid 6 | 0.1 | 0.1 | 0.1 | 0.1 | 0.1 | 0.1 | 0.1 | |
| Caramel 7 | 0.2 | 0.2 | 0.2 | 0.2 | 0.2 | 0.2 | 0.2 | |
| Alcohol 8 | 0.2 | 0.2 | 0.2 | 0.2 | 0.2 | 0.2 | 0.2 | |
| Preservative solution 9 | ad 100 | ad 100 | ad 100 | ad 100 | ad 100 | ad 100 | ad 100 |
| Independent Factors | Code | Level | ||
|---|---|---|---|---|
| CBP concentration | X1 | −1 | 0 | +1 |
| 0.8 | 0.9 | 1 | ||
| Sodium hydroxide amount | X2 | −1 | 0 | +1 |
| 0.3% | 0.35% | 0.4% | ||
| MIC content | X3 | +(gels with MIC) | −(gels without MIC) | |
| Dependent Parameter Name | Code | Measuring Unit |
|---|---|---|
| Consistency | Y1 | mm |
| Spreadability | Y2 | mm2 |
| Destructuring tangential stress, level 1 | Y3 | dyne/cm2 |
| Destructuring tangential stress, level 11 | Y4 | dyne/cm2 |
| Reorganization tangential stress, level 11 | Y5 | dyne/cm2 |
| Reorganization tangential stress, level 1 | Y6 | dyne/cm2 |
| Destructuring viscosity, level 1 | Y7 | Pa × s |
| Destructuring viscosity, level 11 | Y8 | Pa × s |
| >Reorganization viscosity, level 11 | Y9 | Pa × s |
| Reorganization viscosity, level 1 | Y10 | Pa × s |
| Code | Run Order | Y1 | Y2 | Y3 | Y4 | Y5 | Y6 | Y7 | Y8 | Y9 | Y10 |
|---|---|---|---|---|---|---|---|---|---|---|---|
| GO1 | 1 | 27.96 | 3525 | 625.9 | 2333 | 2276 | 740 | 1897 | 29 | 28 | 1897 |
| GO2 | 2 | 23.20 | 2826 | 739 | 3072 | 3015 | 739 | 2241 | 38 | 37 | 2241 |
| GO3 | 3 | 24.03 | 2550 | 769 | 3414 | 3243 | 740 | 1724 | 42 | 40 | 2241 |
| GO4 | 4 | 25.20 | 2920 | 797 | 3357 | 3186 | 796 | 1724 | 41 | 39 | 2413 |
| GO5 | 5 | 25.73 | 2640 | 910 | 3357 | 3015 | 796 | 2758 | 41 | 37 | 2413 |
| GO6 | 6 | 26.23 | 1661 | 739.7 | 2105 | 1878 | 740 | 2241 | 26 | 23 | 2241 |
| GO7 | 7 | 28.56 | 1384 | 2457 | 5692 | 4269 | 1747 | 7445 | 70 | 52 | 5294 |
| GM1 | 8 | 23.46 | 1610 | 1707 | 3926 | 3584 | 1593 | 5172 | 48 | 44 | 4827 |
| GM2 | 9 | 25.60 | 1756 | 2219 | 3983 | 3414 | 1536 | 6724 | 49 | 42 | 4655 |
| GM3 | 10 | 23.83 | 2826 | 967 | 3129 | 3129 | 796 | 2931 | 38 | 38 | 2413 |
| GM4 | 11 | 23.73 | 2550 | 739 | 2788 | 2674 | 569 | 2241 | 34 | 33 | 1724 |
| GM5 | 12 | 29.60 | 2122 | 1650 | 2901 | 2560 | 1194 | 5000 | 35 | 31 | 3620 |
| GM6 | 13 | 29.03 | 2461 | 1081 | 2560 | 2503 | 853 | 3276 | 31 | 30 | 2586 |
| GM7 | 14 | 28.52 | 2205 | 1422 | 3186 | 3129 | 796 | 4310 | 39 | 38 | 2413 |
| Code | Summary of Fit | ANOVA Test | ||
|---|---|---|---|---|
| R2 Adj | RSD | p-Value | Lack of Fit | |
| Y1 | 0.78 | 1.114 | 0.005 | 0.210 |
| Y2 | 0.78 | 0.045 | <0.001 | 0.062 |
| Y3 | 0.97 | 126.3 | <0.001 | 0.609 |
| Y4 | 0.79 | 0.037 | 0.009 | 0.486 |
| Y5 | 0.76 | 297.8 | 0.012 | 0.377 |
| Y6 | 0.81 | 208.9 | 0.001 | 0.358 |
| Y7 | 0.81 | 896.8 | <0.001 | 0.199 |
| Y8 | 0.75 | 0.055 | 0.014 | 0.329 |
| Y9 | 0.78 | 3.480 | 0.010 | 0.348 |
| Y10 | 0.92 | 417.8 | <0.001 | 0.527 |
| Code | Drug Content (% w/w) ± SD |
|---|---|
| GM1 | 2.148 ± 0.0290 |
| GM2 | 2.207 ± 0.0127 |
| GM3 | 1.743 ± 0.0219 |
| GM4 | 2.284 ± 0.0066 |
| GM5 | 2.293 ± 0.0071 |
| GM6 | 1.896 ± 0.0132 |
| GM7 | 2.212 ± 0.0112 |
| Name | Predicted Min | Predicted Max | Experimental Data | Fitting Prediction |
|---|---|---|---|---|
| Y1 | 22.38 | 32.47 | 22.4 | Yes |
| Y2 | 1855.13 | 2714.78 | 2462 | Yes |
| Y3 | 735.51 | 2337.64 | 569 | <Predicted min |
| Y4 | 2190.17 | 3803.76 | 2788 | Yes |
| Y5 | 2030.53 | 3981.38 | 2731 | Yes |
| Y6 | 17.22 | 1533.82 | 739 | Yes |
| Y7 | 1613.38 | 6913.43 | 1724 | Yes |
| Y8 | 26.73 | 60.9042 | 34.42 | Yes |
| Y9 | 24.94 | 48.6021 | 34 | Yes |
| Y10 | 52.21 | 4905.9 | 2242 | Yes |
Publisher’s Note: MDPI stays neutral with regard to jurisdictional claims in published maps and institutional affiliations. |
© 2022 by the authors. Licensee MDPI, Basel, Switzerland. This article is an open access article distributed under the terms and conditions of the Creative Commons Attribution (CC BY) license (https://creativecommons.org/licenses/by/4.0/).
Share and Cite
Pintea, A.; Vlad, R.-A.; Antonoaea, P.; Rédai, E.M.; Todoran, N.; Barabás, E.-C.; Ciurba, A. Structural Characterization and Optimization of a Miconazole Oral Gel. Polymers 2022, 14, 5011. https://doi.org/10.3390/polym14225011
Pintea A, Vlad R-A, Antonoaea P, Rédai EM, Todoran N, Barabás E-C, Ciurba A. Structural Characterization and Optimization of a Miconazole Oral Gel. Polymers. 2022; 14(22):5011. https://doi.org/10.3390/polym14225011
Chicago/Turabian StylePintea, Andrada, Robert-Alexandru Vlad, Paula Antonoaea, Emöke Margit Rédai, Nicoleta Todoran, Enikő-Csilla Barabás, and Adriana Ciurba. 2022. "Structural Characterization and Optimization of a Miconazole Oral Gel" Polymers 14, no. 22: 5011. https://doi.org/10.3390/polym14225011
APA StylePintea, A., Vlad, R.-A., Antonoaea, P., Rédai, E. M., Todoran, N., Barabás, E.-C., & Ciurba, A. (2022). Structural Characterization and Optimization of a Miconazole Oral Gel. Polymers, 14(22), 5011. https://doi.org/10.3390/polym14225011

